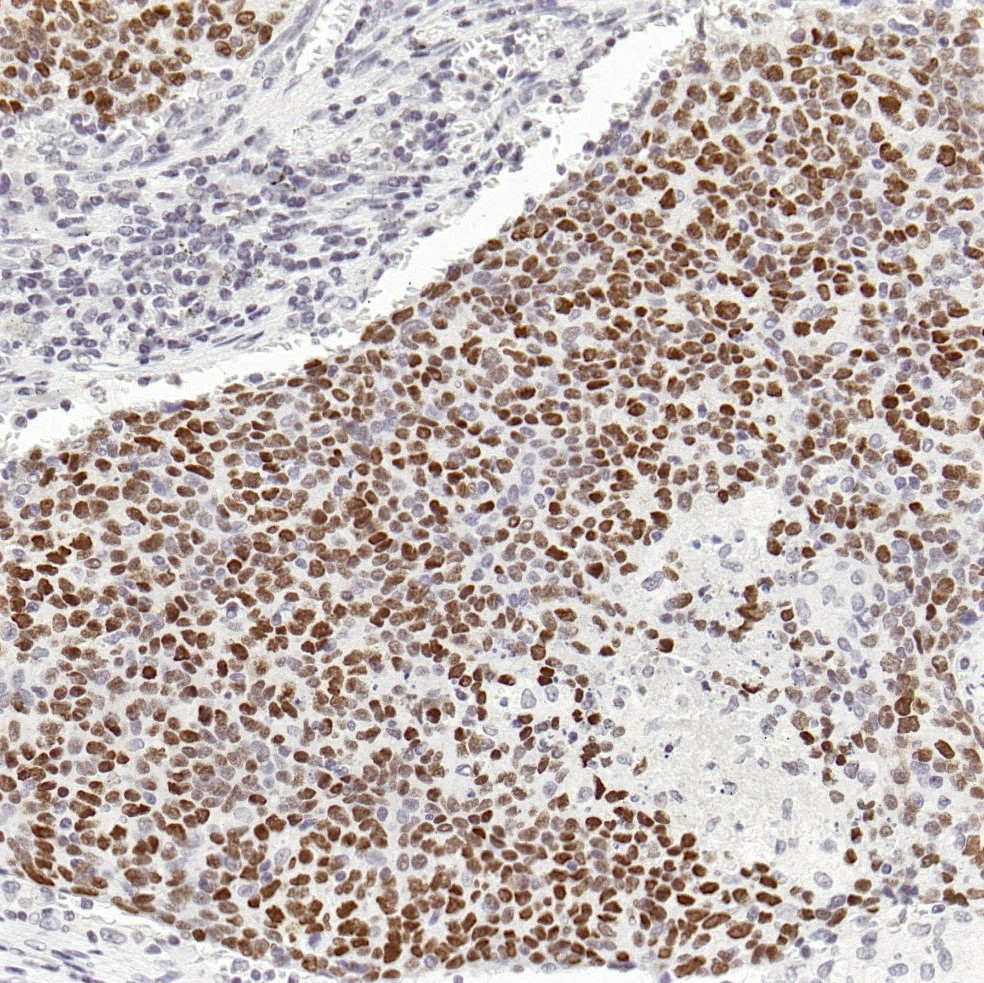
肺癌EBER探针染色
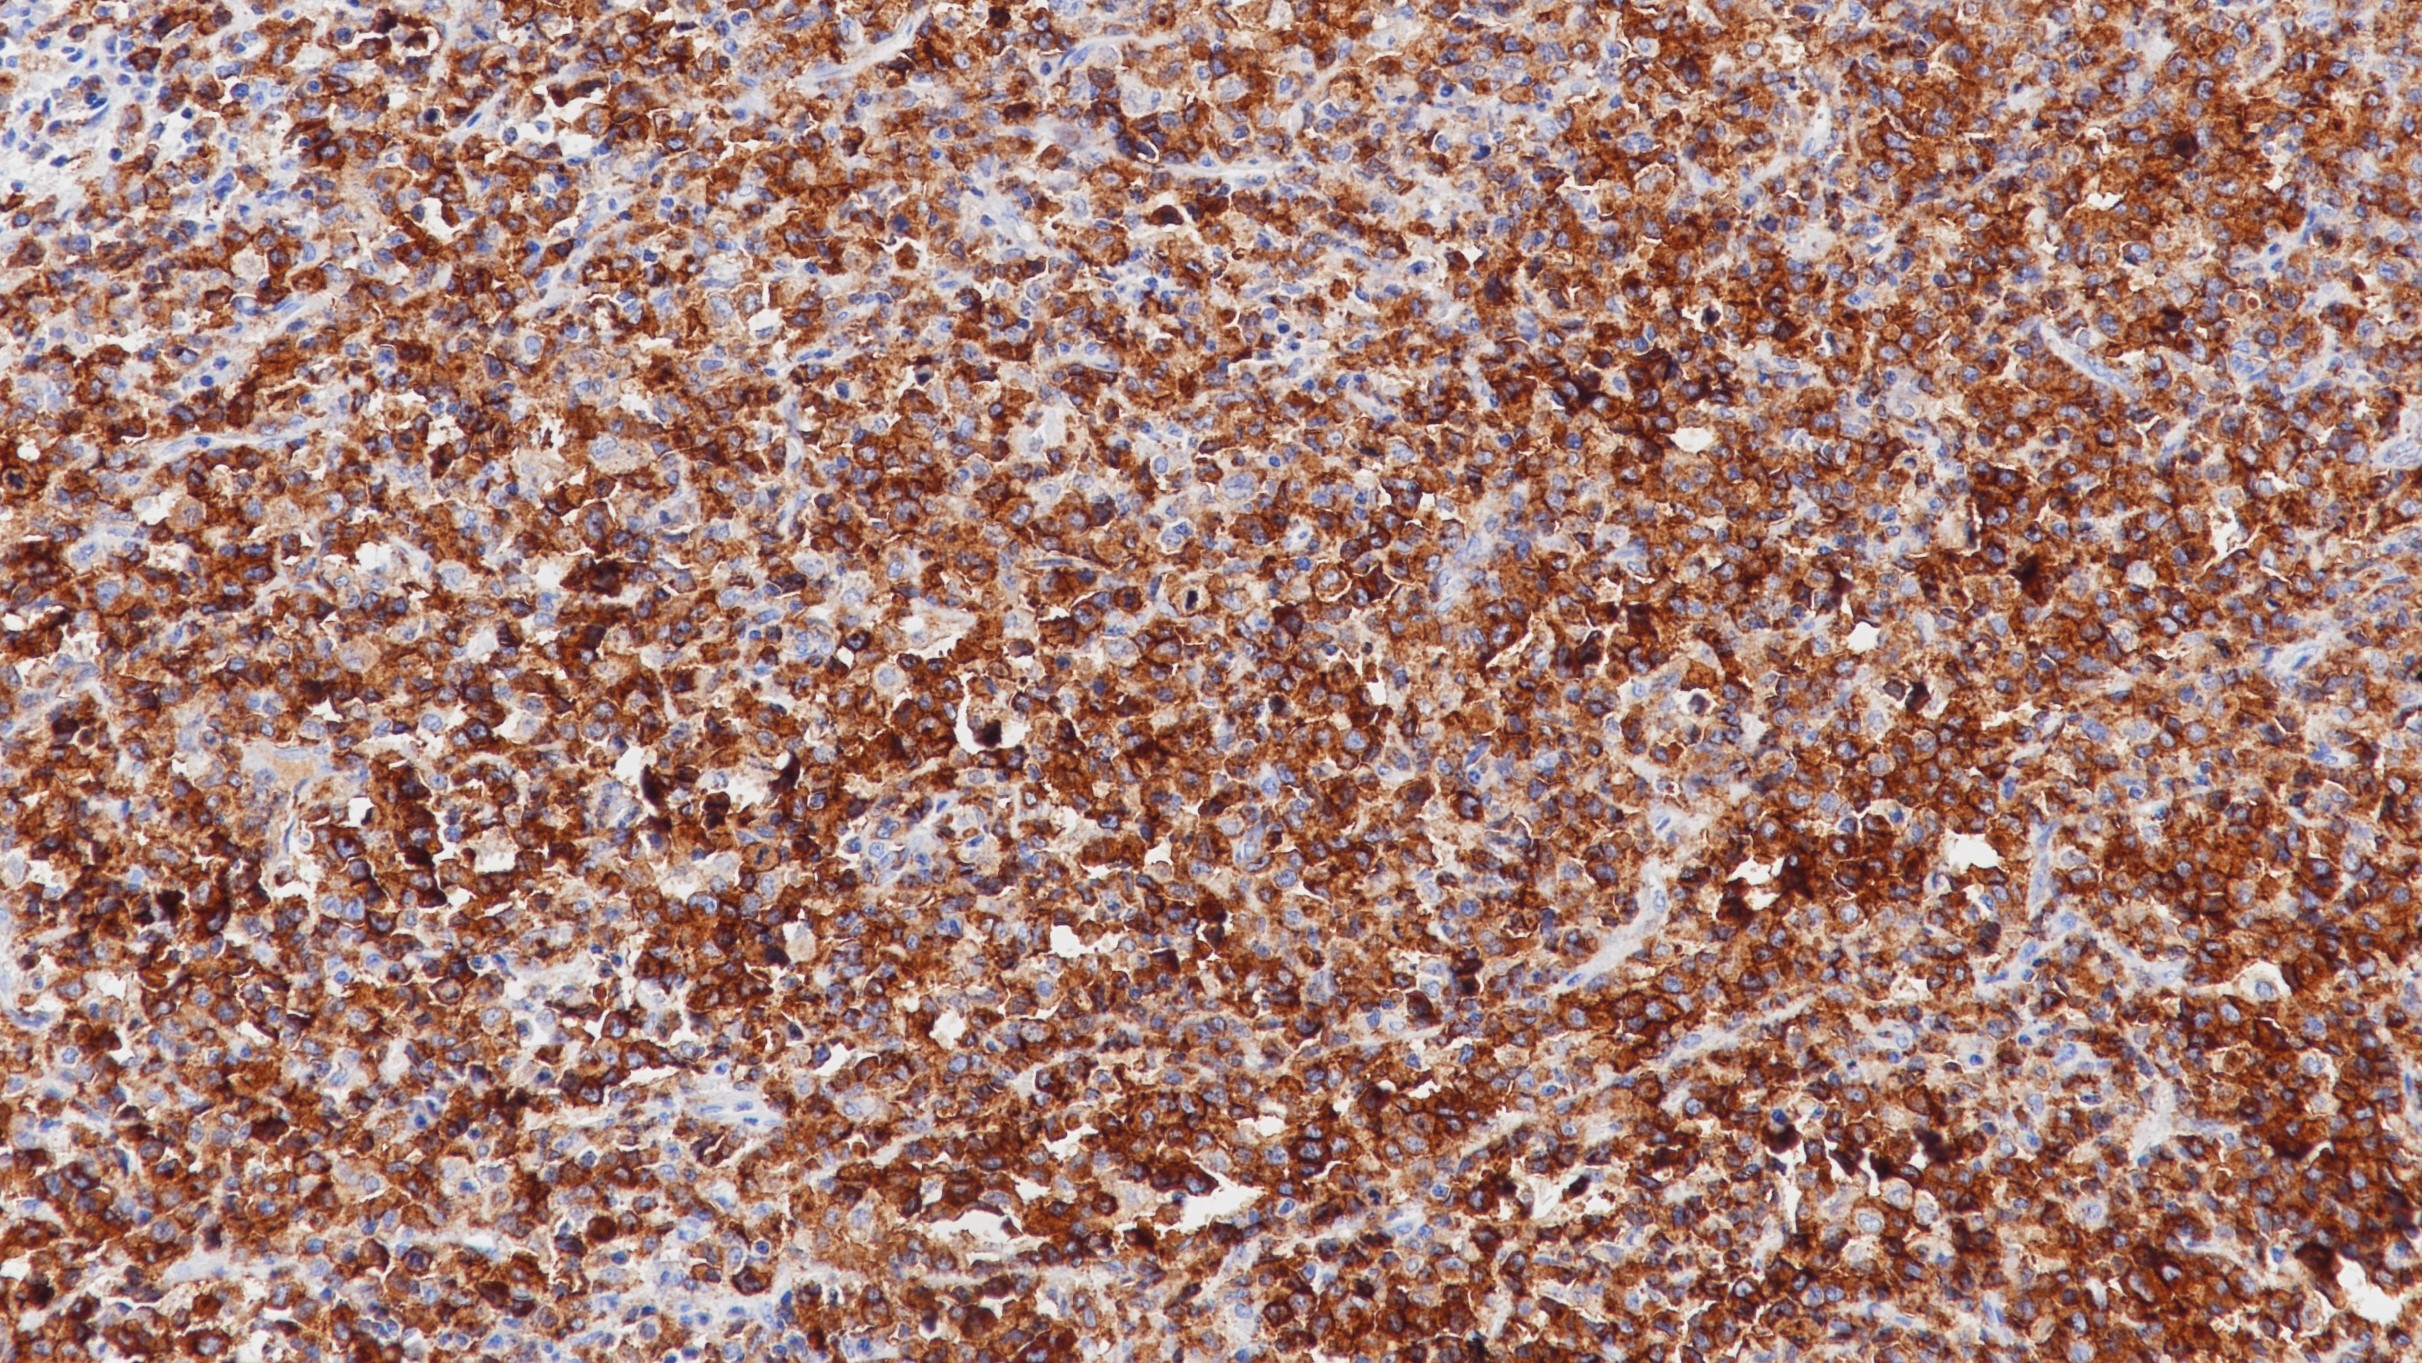

产品中心

鼻咽癌EBER探针染色
肺癌EBER探针染色

伯基特淋巴瘤EBER染色
EBER 原位杂交探针
EB病毒是一种嗜淋巴细胞疱疹病毒,被国际癌症研究署列为致癌因子之一。EBER是EB病毒编码的小mRNA产物,存在于EB病毒潜伏期、复制期等各个时期。原位杂交检测EBERs能够定位EBV感染的细胞类型,是明确肿瘤与EBV相关的金标准。百凌生物全新推出EBER探针(原位杂交法)试剂,适用于石蜡包埋组织样本及细胞样本,适配LYNX480全自动免疫组化仪器,染色流程经过优化设置,可实现全流程标准化管理,精准快捷高效检出EBER1 & EBER2,明确EBV感染情况。
Specifications
- 产品注册名称
- EBER探针(原位杂交法)
- 目录号
- I1243
- 规格
- 50测试/盒
100测试/盒
- 用途
- NMPA IVD
Applicable platform
- Biolynx平台
- Leica平台
- Roche平台
- Dako平台